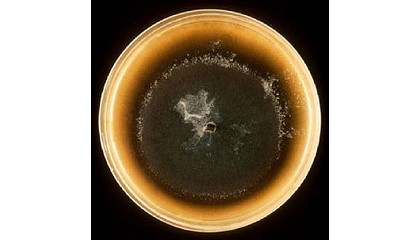

Resultados de la búsqueda "AIDIMA"
La AEI Madera-Mueble de la Comunidad Valenciana promueve una plataforma de transferencia del conocimiento para el sector - 05/04/2013
Aidima ), poner en marcha un plataforma de transferencia del conocimiento que permita asegurar la competitividad de las empresas participantes, así como su visibilidad y mayor presencia en los mercados internacionales
Nuevas formulaciones de recubrimientos mediante la utilización de nanoaditivos - 10/01/2012

Aidima, este último coordinador, han estado desarrollando en colaboración un proyecto financiado por el Impiva y el Fondo Europeo de Desarrollo Regional, y titulado Investigación de nuevas formulaciones de recubrimientos
Renovarse sin reticencias - 31/05/2011

Aidima. Foto: Aidima. El curso Innovando en la Gestión Empresarial, enfocado a directivos del sector maderero, ha llegado a su cuarta edición, y con tanta demanda que se repetirá en noviembre
Materializa apuesta por la naturaleza como fuente de innovación en materiales - 03/05/2012
Aidima , no sólo se identifica y selecciona los nuevos materiales que están en el mercado, sino también se analizan y se agrupan en tendencias para aportar a las empresas del sector
Una alternativa para la madera azul - 02/11/2010
Aidima) está desarrollando y ensayando diferentes fórmulas de éxito para combatir el hongo azulado que ataca las especies de pino más utilizadas por la industria para ayudar a la industria
Aimplas y Aidima participan en un proyecto de etiquetado inteligente que sustituirá al código de barras - 26/10/2009
Aidima participan en un proyecto de etiquetado inteligente que sustituirá al código de barras - 26/10/2009: Aimplas y Aidima participan en un proyecto de etiquetado inteligente que sustituirá al código de barras
Seis Institutos Tecnológicos trabajan de forma conjunta en tecnologías de unión - 17/01/2013
Aidima , Aidico e ITC, pretende asentar la infraestructura necesaria y realizar conjuntamente investigaciones y desarrollos concretos sobre tecnologías de unión en toda su amplitud: adhesivos, recubrimientos, pinturas, así como tratamientos
Entrevista a Miguel Bixquert, director de Fimma-Maderalia - 04/11/2011

Aidima. Lo de los nuevos materiales ha sido una apuesta bastante global: las bibliotecas de materiales del Instituto Tecnológico del Mueble, Madera, Embalaje y Afines (Aidima) y del Centro de Difusión
Fedemco hace recuento de sus principales acciones durante 2012 - 31/05/2013

Aidima. También puso de relieve el seguimiento y apoyo en la implementación de las Buenas Prácticas de Fabricación e Higiene en las empresas. En cuanto a Medio Ambiente, se refirió
Jornada Gestión de la calidad en los procesos de la organización - 02/03/2012

Aidima. Enrique Rueda, del Dpto. de Logística y Tecnología de Procesos de Aidima, expuso los diferentes conceptos relacionados con el control, el aseguramiento y la calidad total, destacando la utilidad
Aidima ayuda en la redacción de los pliegos de condiciones para concursos públicos - 02/02/2010
Aidima ayuda en la redacción de los pliegos de condiciones para concursos públicos - 02/02/2010: Aidima ayuda en la redacción de los pliegos de condiciones para concursos públicos 2 de febrero
Multinkjet aportará nuevas funciones a los envases con el uso de tintas - 29/10/2012

Aidima) y de la Óptica, el Color e Imagen (Aido), todos ellos miembros de Redit. La tecnología inkjet consiste en la impresión mediante deposición de tinta gota a gota. Frente
EMUCA se consolida en la senda del crecimiento para alcanzar 40 millones de euros de facturación - 31/05/2012
AIDIMA, indica el Director General de EMUCA, Enrique Albargues. Precisamente, con el Instituto Tecnológico del Mueble, Madera, Embalaje y Afines, AIDIMA, hemos definido distintos escenarios donde ubicar nuestros perfiles de clientes
Fedemco organiza una jornada sobre 'Sistemas de Secado y Tratamiento Térmico' - 07/02/2012

Aidima ), organizó el 31 de enero, en las instalaciones del Instituto Tecnológico, la jornada Sistemas de control en tecnologías de secado y tratamiento térmico (HT). La jornada, subvencionada por el Servicio
Un nuevo modelo de negocio que se ajusta a los cambios en el consumo - 13/03/2013

AIDIMA plantean un escenario complejo de consumo con hasta 1.100 alternativas de consumidor y múltiples variables en la configuración de los hogares, por lo que el nuevo modelo de negocio
Oportunidades de los residuos de envase y embalaje como combustibles alternativos - 23/12/2012

Aidima e ITC, que estudian otras vertientes de residuos al objeto de encontrar diferentes estrategias de valorización desarrolladas de forma transversal entre los respectivos sectores de actividad y por lo tanto
La nueva gran superficie del hábitat y el bricolaje, Teyoland, ofrecerá el mejor producto y diseño «Hecho en España» - 09/03/2013
AIDIMA plantean un escenario complejo de consumo con hasta 1.100 alternativas de consumidor y múltiples variables en la configuración de los hogares, por lo que el nuevo modelo de negocio
Aidico investiga nuevos procesos para valorizar residuos industriales - 05/12/2012

Aidima; y el propio Aidico, centros con amplia experiencia en el desarrollo tecnológico de cada uno de los sectores industriales para los que desarrollan sus capacidades. Con el propósito de generar
Plataformas informáticas de gestión de redes de fabricación para incrementar la competitividad - 27/02/2012

Aidima, en Paterna (Valencia). Las redes virtuales de fabricación global están formadas por empresas que establecen una colaboración basada en los beneficios que obtienen por la pertenencia a la red para
La madera y la innovación del sector del mueble, buque insignia del programa de jornadas técnicas de la Feria del Mueble de Galicia - 03/09/2012
Aidima) y Montserrat Rodriguez Ojea (Cis Madera). Con esta temática, se pretende según los técnicos .. «trasladar a los asistentes información a cerca de las herramientas de que dispone el sector
